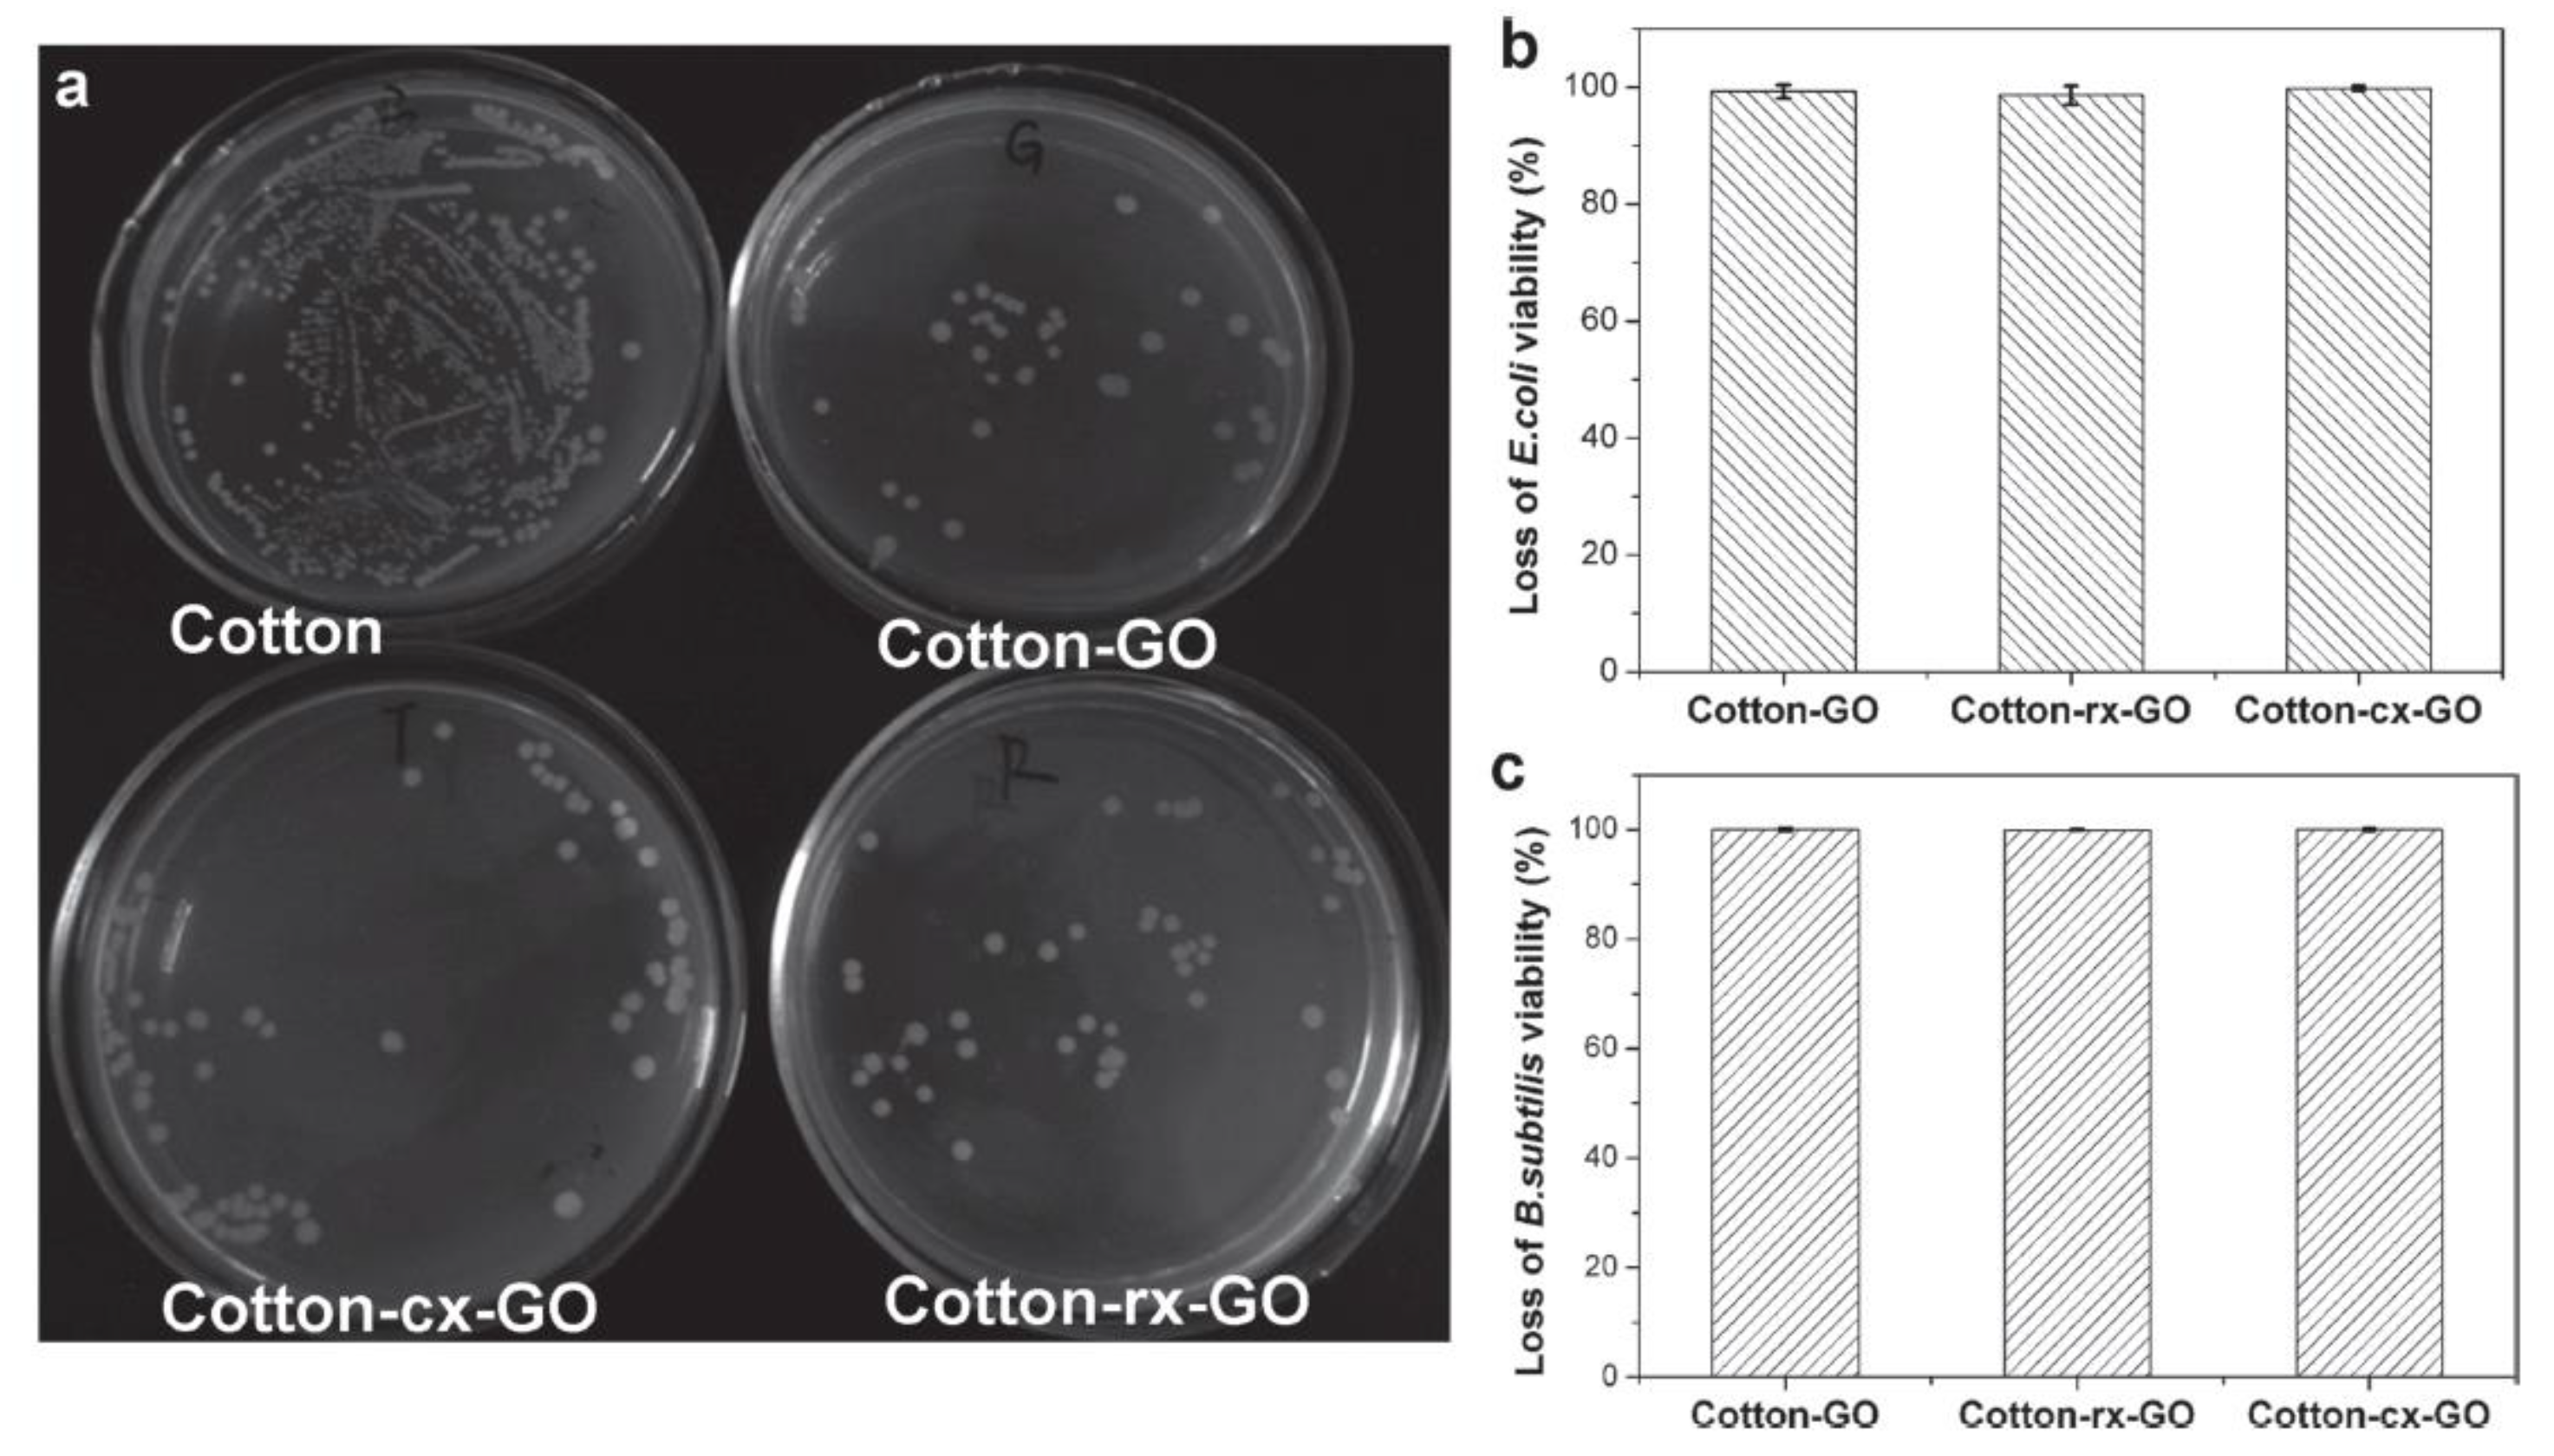
Coatings 13 01580 g005 Coatings 13 01580 g005

Functionalization of Fabrics with Graphene-Based Coatings: Mechanisms, Approaches, and Functions
Abstract
1. Introduction
2. Functionalization of Fabrics Using Graphene Based Coatings: The Concept and Mechanism
3. Functionalization of Fabrics Using Graphene Based Coatings: Applications
3.1. Anti-Bacteria
3.2. UV Protection and Photocatalyst
3.3. Tunable Superwettability and Separation Property
3.4. Electromechanical and Sensory Properties
4. Conclusions
Author Contributions
Funding
Institutional Review Board Statement
Informed Consent Statement
Data Availability Statement
Acknowledgments
Conflicts of Interest
References
- Zhu, Y.; Murali, S.; Cai, W.; Li, X.; Suk, J.W.; Potts, J.R.; Ruoff, R.S. Graphene and graphene oxide: Synthesis, properties, and applications. Adv. Mater. 2010, 22, 3906–3924. [Google Scholar] [CrossRef]
- Wang, H.; Wang, H.S.; Ma, C.; Chen, L.; Jiang, C.; Chen, C.; Xie, X.; Li, A.; Wang, X. Graphene nanoribbons for quantum electronics. Nat. Phys. 2021, 3, 791–802. [Google Scholar] [CrossRef]
- Cao, K.; Feng, S.; Han, Y.; Gao, L.; Ly, T.H.; Xu, Z.; Lu, Y. Elastic straining of free-standing monolayer graphene. Nat. Commun. 2020, 11, 284. [Google Scholar] [CrossRef] [PubMed]
- Balandin, A.A.; Ghosh, S.; Nika, D.L.; Pokatilov, E.P. Thermal conduction in suspended graphene layers. Fuller. Nanotub. Carbon Nanostructures 2010, 18, 474–486. [Google Scholar] [CrossRef]
- Dreyer, D.R.; Park, S.; Bielawski, C.W.; Ruoff, R.S. The chemistry of graphene oxide. Chem. Soc. Rev. 2010, 39, 228–240. [Google Scholar] [CrossRef]
- Chua, C.K.; Pumera, M. Chemical reduction of graphene oxide: A synthetic chemistry viewpoint. Chem. Soc. Rev. 2014, 43, 291–312. [Google Scholar] [CrossRef] [PubMed]
- Liu, F.; Wang, C.; Sui, X.; Riaz, M.A.; Xu, M.; Wei, L.; Chen, Y. Synthesis of graphene materials by electrochemical exfoliation: Recent progress and future potential. Carbon Energy 2019, 1, 173–199. [Google Scholar] [CrossRef]
- Moon, J.; Kim, M.; Kim, S.; Xu, S.; Choi, J.; Whang, D.; Watanabe, K.; Taniguchi, T.; Park, D.S.; Seo, J.; et al. Layer-engineered large-area exfoliation of graphene. Sci. Adv. 2020, 6, eabc6601. [Google Scholar] [CrossRef]
- Williams, G.; Seger, B.; Kamat, P.V. TiO2-graphene nanocomposites. UV-assisted photocatalytic reduction of graphene oxide. ACS Nano 2008, 2, 1487–1491. [Google Scholar] [CrossRef]
- Ma, H.; Chen, X.; Mohammed, S.; Hu, Y.; Lu, J.; Simon, G.P.; Hou, H.; Wang, H. A thermally reduced graphene oxide membrane interlayered with an in situ synthesized nanospacer for water desalination. J. Mater. Chem. A 2020, 8, 25951–25958. [Google Scholar] [CrossRef]
- Lin, Y.M.; Garcia, A.V.; Han, S.J.; Farmer, D.B.; Meric, I.; Sun, Y.; Wu, Y.; Dimitrakopoulos, C.; Grill, A.; Avouris, P.; et al. Wafer-scale graphene integrated circuit. Science 2011, 332, 1294–1297. [Google Scholar] [CrossRef]
- Liu, C.; Chen, Q.; Liu, C.; Zhong, Z. Graphene ambipolar nanoelectronics for high noise rejection amplification. Nano Lett. 2016, 16, 1064–1068. [Google Scholar] [CrossRef] [PubMed]
- Bunch, J.S.; Verbridge, S.S.; Alden, J.S.; Zande, A.M.; Parpia, J.M.; Craighead, H.G.; McEuen, P.L. Impermeable atomic membranes from graphene sheets. Nano Lett. 2008, 8, 2458–2462. [Google Scholar] [CrossRef] [PubMed]
- Dong, Z.; Jiang, C.; Cheng, H.; Zhao, Y.; Shi, G.; Jiang, L.; Qu, L. Facile fabrication of light, flexible and multifunctional graphene fibers. Adv. Mater. 2012, 24, 1856–1861. [Google Scholar] [CrossRef] [PubMed]
- Yu, G.; Hu, L.; Vosgueritchian, M.; Wang, H.; Xie, X.; McDonough, J.R.; Cui, X.; Cui, Y.; Bao, Z. Solution-processed graphene/MnO2 nanostructured textiles for high-performance electrochemical supercapacitors. Nano Lett. 2011, 11, 2905–2911. [Google Scholar] [CrossRef]
- Hong, X.; Yu, R.; Hou, M.; Jin, Z.; Dong, Y.; Zhu, C.; Wan, J.; Li, Y. Smart fabric strain sensor comprising reduced graphene oxide with structure-based negative piezoresistivity. J. Mater. Sci. 2021, 56, 16946–16962. [Google Scholar] [CrossRef]
- Lerf, A.; He, H.; Forster, M.; Klinowski, J. Structure of graphene oxide revisited. J. Phys. Chem. B 1998, 102, 4477–4482. [Google Scholar] [CrossRef]
- Kim, J.; Cote, L.J.; Kim, F.; Yuan, W.; Shull, K.R.; Huang, J. Graphene oxide sheets at interfaces. J. Am. Chem. Soc. 2010, 132, 8180–8186. [Google Scholar] [CrossRef]
- Withers, N. Surfactant sheets. Nat. Chem. 2010. [Google Scholar] [CrossRef]
- Luo, J.; Yang, L.; Sun, D.; Gao, Z.; Jiao, K.; Zhang, J. Graphene oxide “surfactant”-directed tunable concentration of graphene dispersion. Small 2020, 16, 2003426. [Google Scholar] [CrossRef]
- Wang, S.; Chia, P.J.; Chua, L.L.; Zhao, L.H.; Png, R.Q.; Sivaramakrishnan, S.; Zhou, M.; Goh, R.G.S.; Friend, R.H.; Wee, A.T.S.; et al. Band-like transport in surface-functionalized highly solution-processable graphene nanosheets. Adv. Mater. 2008, 20, 3440–3446. [Google Scholar] [CrossRef]
- Li, B.; Hou, W.; Sun, J.; Jiang, S.; Xu, L.; Li, G.; Memon, M.A.; Cao, J.; Huang, Y.; Bielawski, C.W.; et al. Tunable functionalization of graphene oxide sheets through surface-initiated cationic polymerization. Macromolecules 2015, 48, 994–1001. [Google Scholar] [CrossRef]
- Guo, S.; Garaj, S.; Bianco, A.; Ménard-Moyon, C. Controlling covalent chemistry on graphene oxide. Nat. Rev. Phys. 2022, 4, 247–262. [Google Scholar] [CrossRef]
- Aujara, K.M.; Chieng, B.W.; Ibrahim, N.A.; Zainuddin, N.; Ratnam, C.T. Gamma-irradiation induced functionalization of graphene oxide with organosilanes. Int. J. Mol. Sci. 2019, 20, 1910. [Google Scholar] [CrossRef] [PubMed]
- Pyun, J. Graphene oxide as catalyst: Application of carbon materials beyond nanotechnology. Angew. Chem. Int. Ed. 2011, 50, 46–48. [Google Scholar] [CrossRef]
- Sharma, N.; Swami, S.; Shrivastava, V.; Nair, R.; Shrivastava, R. Graphene oxide and functionalized graphene oxide: Robust, 2D material as heterogeneous green catalyst for heterocyclic synthesis. Mater. Today Proc. 2021, 43, 3309–3317. [Google Scholar] [CrossRef]
- Yuan, S.; Wang, J.; Mei, J.; Zhao, J.; Huang, G.; Li, Z.; He, X.; Fan, J. Fabric comprised of cotton impregnated with graphene oxide and coated with polystyrene for personal moisture and thermal management. ACS Appl. Nano Mater. 2023, 6, 4499–4510. [Google Scholar] [CrossRef]
- Zhou, J.; Luo, Q.; Gao, P.; Ma, H. Assembly of graphene oxide on cotton fiber through dyeing and their properties. RSC Adv. 2020, 10, 11982–11989. [Google Scholar] [CrossRef]
- Khoso, N.A.; Xu, G.; Xie, J.; Sun, T.; Wang, J. The fabrication of a graphene and conductive polymer nanocomposite-coated highly flexible and washable woven thermoelectric nanogenerator. Mater. Adv. 2021, 2, 3695–3704. [Google Scholar] [CrossRef]
- Shathi, M.A.; Chen, M.; Khoso, N.A.; Rahman, M.T.; Bhattacharjee, B. Graphene coated textile based highly flexible and washable sports bra for human health monitoring. Mater. Des. 2020, 193, 108792. [Google Scholar] [CrossRef]
- Yang, S.; Sha, S.; Lu, H.; Wu, J.; Ma, J.; Wang, D.; Hou, C.; Sheng, Z. Graphene oxide and reduced graphene oxide coated cotton fabrics with opposite wettability for continuous oil/water separation. Sep. Purif. Technol. 2021, 259, 118095. [Google Scholar] [CrossRef]
- Shateri-Khalilabad, M.; Yazdanshenas, M.E. Fabricating electroconductive cotton textiles using graphene. Carbohydr. Polym. 2013, 96, 190–195. [Google Scholar] [CrossRef] [PubMed]
- Chen, F.; Liu, H.; Xu, M.; Ye, J.; Li, Z.; Qin, L.; Zhang, T. Flexible cotton fabric with stable conductive coatings for piezoresistive sensors. Cellulose 2021, 28, 10025–10038. [Google Scholar] [CrossRef]
- Shateri-Khalilabad, M.; Yazdanshenas, M.E. Preparation of superhydrophobic electroconductive graphene-coated cotton cellulose. Cellulose 2013, 20, 963–972. [Google Scholar] [CrossRef]
- Karim, N.; Afroj, S.; Tan, S.; He, P.; Fernando, A.; Carr, C.; Novoselov, K.S. Scalable production of graphene-based wearable E-Textiles. ACS Nano 2017, 11, 12266–12275. [Google Scholar] [CrossRef]
- Fugetsu, B.; Sano, E.; Yu, H.; Mori, K.; Tanaka, T. aoxide as dyestuffs for the creation of electrically conductive fabrics. Carbon 2010, 48, 3340–3345. [Google Scholar] [CrossRef]
- Krishnamoorthy, K.; Navaneethaiyer, U.; Mohan, R.; Lee, J.; Kim, S. Graphene oxide nanostructures modified multifunctional cotton fabrics. Appl. Nanosci. 2012, 2, 119–216. [Google Scholar] [CrossRef]
- Molina, J.; Fernandez, J.; Rio, A.I.; Bonastre, J.; Cases, F. Chemical and electrochemical study of fabrics coated with reduced graphene oxide. Appl. Surf. Sci. 2013, 279, 46–54. [Google Scholar] [CrossRef]
- Yang, F.; Lan, C.; Zhang, H.; Guan, J.; Zhang, F.; Fei, B.; Zhang, J. Study on graphene/CNC-coated bamboo pulp fabric: Preparation of fabrics with thermal conductivity. Polymers 2019, 11, 1265. [Google Scholar] [CrossRef]
- Yun, Y.J.; Hong, W.G.; Kim, W.; Jun, Y.; Kim, B.H. A novel method for applying reduced graphene oxide directly to electronic textiles from yarns to fabrics. Adv. Mater. 2013, 25, 5701–5705. [Google Scholar] [CrossRef]
- Khoso, N.A.; Xie, J.; Xu, G.; Sun, T.; Wang, J. Enhanced thermoelectric performance of graphene based nanocomposite coated self-powered wearable e-textiles for energy harvesting from human body heat. RSC Adv. 2021, 11, 16675–16687. [Google Scholar] [CrossRef] [PubMed]
- Kumar, A.; Kebaili, I.; Boukhris, I.; Vaish, R.; Kumar, A.; Park, H.K.B.; Joo, Y.H.; Sung, T.H. Cotton functionalized with polyethylene glycol and graphene oxide for dual thermoregulating and UV-protection applications. Sci. Rep. 2023, 13, 5923. [Google Scholar] [CrossRef]
- Manasoglu, G.; Celen, R.; Kanik, M.; Ulcay, Y. Electrical resistivity and thermal conductivity properties of graphene-coated woven fabrics. J. Appl. Polym. Sci. 2019, 136, 48024. [Google Scholar] [CrossRef]
- Hunter, C.A.; Sanders, J.K.M. The nature of π-π interactions. J. Am. Chem. Soc. 1990, 112, 5525–5534. [Google Scholar] [CrossRef]
- Farouk, A.; Saeed, S.E.; Sharaf, S.; El-Hady, M.M.A. Photocatalytic activity and antibacterial properties of linen fabric using reduced graphene oxide/silver nanocomposite. RSC Adv. 2020, 10, 41600–41611. [Google Scholar] [CrossRef]
- Pedrosa, M.; Sampaio, M.J.; Horvat, T.; Nunes, O.C.; Dražić, G.; Rodrigues, A.E.; Figueiredo, J.L.; Silva, C.G.; Silva, A.M.T.; Faria, J.L. Visible-light-induced self-cleaning functional fabrics using graphene oxide/carbon nitride materials. Appl. Surf. Sci. 2019, 497, 143757. [Google Scholar] [CrossRef]
- Gong, T.; Kim, J.; Woo, J.Y.; Jang, J.; Lee, S.E.; Han, C. Fabrics coated with hot-iron-treated graphene oxide for a self-cleaning and mechanically robust water-oil separation material. RSC Adv. 2017, 7, 25796–25802. [Google Scholar] [CrossRef]
- Rafiee, J.; Rafiee, M.A.; Yu, Z.; Koratkar, N. Superhydrophobic to superhydrophilic wetting control in graphene films. Adv. Mater. 2010, 22, 2151–2154. [Google Scholar] [CrossRef]
- Liu, Y.; Wang, X.; Fei, B.; Hu, H.; Lai, C.; Xin, J.H. Bioinspired, stimuli-responsive, multifunctional superhydrophobic surface with directional wetting, adhesion, and transport of water. Adv. Funct. Mater. 2015, 25, 5047–5056. [Google Scholar] [CrossRef]
- Liu, S.; Zeng, T.H.; Hofmann, M.; Burcombe, E.; Wei, J.; Jiang, R.; Kong, J.; Chen, Y. Antibacterial activity of graphite, graphite oxide, graphene oxide, and reduced graphene oxide: Membrane and oxidative stresses. ACS Nano 2011, 5, 6971–6980. [Google Scholar] [CrossRef]
- Zhao, J.; Deng, B.; Lv, M.; Li, J.; Zhang, Y.; Jiang, H.; Peng, C.; Li, J.; Shi, J.; Huang, Q.; et al. Graphene-oxide based antibacterial cotton fabrics. Adv. Healthc. Mater. 2013, 2, 1259–1266. [Google Scholar] [CrossRef]
- Liu, Y.; Wang, X.; Qi, K.; Xin, J.H. Functionalization of cotton with carbon nanotubes. J. Mater. Chem. 2008, 18, 3454–3460. [Google Scholar] [CrossRef]
- Yaghoubidoust, F.; Salimi, E. A simple method for the preparation of antibacterial cotton fabrics by coating graphene oxide nanosheets. Fibers Polym. 2019, 20, 1155–1160. [Google Scholar] [CrossRef]
- Yadav, N.; Dubey, A.; Shukla, S.; Saini, C.P.; Gupta, G.; Priyadarshini, R.; Lochab, B. Graphene oxide-coated surface: Inhibition of bacterial biofilm formation due to specific surface-interface interactions. ACS Omega 2017, 2, 3070–3082. [Google Scholar] [CrossRef] [PubMed]
- Mizerska, U.; Fortuniak, W.; Makowski, T.; Svyntkivska, M.; Piorkowska, E.; Kowalczyk, D.; Brzezinski, S.; Kregiel, D. Antibacterial electroconductive rGO modified cotton fabric. Polym. Adv. Technol. 2021, 32, 3975–3981. [Google Scholar] [CrossRef]
- Xu, Z.; Pan, N.; Xue, Y.; Jiang, T.; Wang, Y. Long-lasting renewable antibacterial graphene/N-halamine-coated cotton fabrics benefitting from enhanced UV stability and quantitative tracking of bactericidal factors. Int. J. Biol. Macromol. 2022, 222, 1192–1200. [Google Scholar] [CrossRef]
- Kim, J.; Kang, S.H.; Choi, Y.; Lee, W.; Kim, N.; Tanaka, M.; Kang, S.H.; Choi, J. Antibacterial and biofilm-inhibiting cotton fabrics decorated with copper nanoparticles grown on graphene nanosheets. Sci. Rep. 2023, 13, 11947. [Google Scholar] [CrossRef] [PubMed]
- Jafari, B.; Lacerda, C.M.R.; Botte, G.G. Facile electrochemical preparation of hydrophobic antibacterial fabrics using reduced graphene oxide/silver nanoparticles. ChemElectroChem 2023, 10, e202201111. [Google Scholar] [CrossRef]
- Rodrigues, D.P.; Moreirinha, C.; Rajan, G.; Neves, A.I.S.; Freitas, S.C.; Sequeira, S.; Russo, S.; Craciun, M.F.; Almeida, A.; Alves, H. Conversion of antibacterial activity of graphene-coated textiles through surface polarity. Nano Sel. 2023, 4, 463–524. [Google Scholar] [CrossRef]
- Abdolkarimi-Mahabadi, M.; Bayat, A.; Mohammadi, A. Use of UV-vis spectrophotometry for characterization of carbon nanostructures: A review. Theor. Exp. Chem. 2021, 57, 191–198. [Google Scholar] [CrossRef]
- Senthil, R.A.; Selvi, A.; Arunachalam, P.; Amudha, L.S.; Madhavan, J.; Al-Mayouf, A.M. A sensitive electrochemical detection of hydroquinone using newly synthesized α-Fe2O3-graphene oxide nanocomposite as an electrode material. J. Mater. Sci. 2017, 28, 10081–10091. [Google Scholar] [CrossRef]
- Johra, F.T.; Lee, J.; Jung, W. Facile and safe graphene preparation on solution based platform. J. Ind. Eng. Chem. 2014, 20, 2883–2887. [Google Scholar] [CrossRef]
- He, X.; Liu, Q.; Zhou, Y.; Chen, Z.; Zhu, C.; Jin, W. Graphene oxide-silver/cotton fiber fabric with anti-bacterial and anti-UV properties for wearable gas sensors. Front. Mater. Sci. 2021, 15, 406–415. [Google Scholar] [CrossRef]
- Zuo, D.; Li, G.; Ling, Y.; Cheng, S.; Xu, J.; Zhang, H. Durable UV-blocking property of cotton fabrics with nanocomposite coating based on graphene oxide/ZnO quantum dot via water-based self-assembly. Fibers Polym. 2021, 22, 1837–1843. [Google Scholar] [CrossRef]
- Gültek, B.C. Electrically conductive, hydrophobic, UV protective and lightweight cotton spunlace nonwoven fabric coated with reduced graphene oxide. Turk. J. Chem. 2022, 46, 968–986. [Google Scholar] [CrossRef]
- Zhao, H.; Tian, M.; Hao, Y.; Qu, L.; Zhu, S.; Chen, S. Fast and facile graphene oxide grafting on hydrophobic polyamide fabric via electrophoretic deposition route. J. Mater. Sci. 2018, 53, 9504–9520. [Google Scholar] [CrossRef]
- Bhattacharjee, S.; Macintyre, C.R.; Wen, X.; Bahl, P.; Kumar, U.; Chughtai, A.A.; Joshi, R. Nanoparticles incorporated graphene-based durable cotton fabrics. Carbon 2020, 166, 148–163. [Google Scholar] [CrossRef]
- Xiang, Q.; Yu, J.; Jaroniec, M. Graphene-based semiconductor photocatalysts. Chem. Soc. Rev. 2012, 41, 782–796. [Google Scholar] [CrossRef]
- Liao, G.; Chen, S.; Quan, X.; Yu, H.; Zhao, H. Graphene oxide modified g-C3N4 hybrid with enhanced photocatalytic capability under visible light irradiation. J. Mater. Chem. 2012, 22, 2721–2726. [Google Scholar] [CrossRef]
- Kuang, Y.; Shang, J.; Zhu, T. Photoactivated graphene oxide to enhance photocatalytic reduction of CO2. ACS Appl. Mater. Interfaces 2020, 12, 3580–3591. [Google Scholar] [CrossRef] [PubMed]
- Prasad, C.; Liu, Q.; Tang, H.; Yuvaraja, G.; Long, J.; Rammohan, A.; Zyryanov, G.V. An overview of graphene oxide supported semiconductors based photocatalysts: Properties, synthesis and photocatalytic applications. J. Mol. Liq. 2020, 297, 111826. [Google Scholar] [CrossRef]
- Yeh, T.F.; Cihlar, J.; Chang, C.Y.; Cheng, C.; Teng, H. Roles of graphene oxide in photocatalytic water splitting. Mater. Today 2013, 16, 78–84. [Google Scholar] [CrossRef]
- Zhang, J.; Liu, K.; Sun, S.; Sun, R.; Ma, J. Photo-splitting xylose and xylan to xylonic acid and carbon monoxide. Green Chem. 2022, 24, 8367–8376. [Google Scholar] [CrossRef]
- Yang, X.; Qin, J.; Jiang, Y.; Chen, K.; Yan, X.; Zhang, D.; Li, R.; Tang, H. Fabrication of P25/Ag3PO4/graphene oxide heterostructures for enhanced solar photocatalytic degradation of organic pollutants and bacteria. Appl. Catal. B 2015, 166–167, 231–240. [Google Scholar] [CrossRef]
- Liu, X.; Ma, R.; Wang, X.; Ma, Y.; Yang, Y.; Zhuang, L.; Zhang, S.; Jehan, R.; Chen, J.; Wang, X. Graphene oxide-based materials for efficient removal of heavy metal ions from aqueous solution: A review. Environ. Pollut. 2019, 252, 62–73. [Google Scholar] [CrossRef] [PubMed]
- Qian, D.; Chen, D.; Li, N.; Xu, Q.; Li, H.; He, J.; Lu, J. TiO2/sulfonated graphene oxide/Ag nanoparticle membrane: In situ separation and photodegradation of oil/water emulsions. J. Membr. Sci. 2018, 554, 16–25. [Google Scholar] [CrossRef]
- Yaqoob, A.A.; Noor, N.H.M.; Umar, K.; Adnan, R.; Ibrahim, M.N.M.; Rashid, M. Graphene oxide-ZnO nanocomposite: An efficient visible light photocatalyst for degradation of rhodamine B. Appl. Nanosci. 2021, 11, 1291–1302. [Google Scholar] [CrossRef]
- Sangermano, M.; Calza, P.; Lopez-Manchado, M.A. Graphene oxide-epoxy hybrid material as innovative photocatalyst. J. Mater. Sci. 2013, 48, 5204–5208. [Google Scholar] [CrossRef][Green Version]
- Lu, K.Q.; Li, Y.H.; Tang, Z.R.; Xu, Y.J. Roles of graphene oxide in heterogeneous photocatalysis. ACS Mater. Au 2021, 1, 37–54. [Google Scholar] [CrossRef]
- Qiu, R.; Yuan, S.; Xiao, J.; Chen, X.D.; Selomulya, C.; Zhang, X.; Woo, M.W. Effects of edge functional groups on water transport in graphene oxide membranes. ACS Appl. Mater. Interfaces 2019, 11, 8483–8491. [Google Scholar] [CrossRef]
- Brakat, A.; Zhu, H. Nanocellulose-graphene hybrids: Advanced functional materials as multifunctional sensing platform. Nano-Micro Lett. 2021, 13, 94. [Google Scholar] [CrossRef]
- Tissera, N.D.; Wijesena, R.N.; Perera, J.R.; Silva, K.M.N.; Amaratunge, G.A.J. Hydrophobic cotton textile surfaces using an amphiphilic graphene oxide (GO) coating. Appl. Surf. Sci. 2015, 324, 455–463. [Google Scholar] [CrossRef]
- Liu, Y.; Wang, B.; Wang, Y.; Chen, J.; Cui, B.; Yin, P.; Chen, J.; Zhang, X.; Zhang, L.; Xin, J.H. Bioinspired superhydrophobic surface constructed from hydrophilic building blocks: A case study of core-shell polypyrrole-coated copper nanoneedles. Coatings 2020, 10, 347. [Google Scholar] [CrossRef]
- Cai, G.; Xu, Z.; Yang, M.; Tang, B.; Wang, X. Functionalization of cotton fabrics through thermal reduction of graphene oxide. Appl. Surf. Sci. 2017, 393, 441–448. [Google Scholar] [CrossRef]
- Mizerska, U.; Fortuniak, W.; Makowski, T.; Svyntkivska, M.; Piorkowska, E.; Kowalczyk, D.; Brzezinski, S. Electrically conductive and hydrophobic rGO-containing organosilicon coating of cotton fabric. Prog. Org. Coat. 2019, 137, 105312. [Google Scholar] [CrossRef]
- Berendjchi, A.; Khajavi, R.; Yousefi, A.A.; Yazdanshenas, M.E. Surface characteristics of coated polyester fabric with reduced graphene oxide and polypyrrole. Appl. Surf. Sci. 2016, 367, 36–42. [Google Scholar] [CrossRef]
- Jishnu, A.; Jayan, J.S.; Saritha, A.; Sethulekshmi, A.S.; Venu, G. Superhydrophobic graphene-based materials with self-cleaning and anticorrosion performance: An appraisal of neoteric advancement and future perspectives. Colloids Surf. A 2020, 606, 125395. [Google Scholar]
- Makowski, T.; Svyntkivska, M.; Piorkowska, E.; Mizerska, U.; Fortuniak, W.; Kowalczyk, D.; Brzezinski, S. Conductive and superhydrophobic cotton fabric through pentaerythritol tetrakis(3-(3,5-di-tert-butyl-4-hydroxyphenyl)propionate) assisted thermal reduction of graphene oxide and modification with methyltrichlorosilane. Cellulose 2018, 25, 5377–5388. [Google Scholar] [CrossRef]
- Zhou, X.; Song, W.; Zhu, G. A facile approach for fabricating silica dioxide/reduced graphene oxide coated cotton fabrics with multifunctional properties. Cellulose 2020, 27, 2927–2938. [Google Scholar] [CrossRef]
- Chen, K.; Liu, H.; Zhou, J.; Sun, Y.; Yu, K. Polyurethane blended with silica-nanoparticle-modified graphene as a flexible and superhydrophobic conductive coating with a self-healing ability for sensing applications. ACS Appl. Nano Mater. 2022, 5, 615–625. [Google Scholar] [CrossRef]
- Ni, Y.; Huang, J.; Li, S.; Wang, X.; Liu, L.; Wang, M.; Chen, Z.; Li, X.; Lai, Y. Underwater, multifunctional superhydrophobic sensor for human motion detection. ACS Appl. Mater. Interfaces 2021, 13, 4740–4749. [Google Scholar] [CrossRef] [PubMed]
- Gao, S.; Li, H.; Zheng, L.; Huang, W.; Chen, B.; Lai, X.; Zeng, X. Superhydrophobic and conductive polydimethylsiloxane/titanium dioxide @ reduced graphene oxide coated cotton fabric for human motion detection. Cellulose 2021, 28, 7373–7388. [Google Scholar] [CrossRef]
- Xu, L.; Li, J.; Pan, H.; Wang, L.; Liu, Y.; Shen, Y. Preparation of superhydrophobic cotton fabric with ultraviolet resistance and photocatalysis based on CuS/reduced graphene oxide. ChemistrySelect 2023, 8, e202300167. [Google Scholar] [CrossRef]
- Guo, G.; Liu, L.; Zhang, Q.; Pan, C.; Zou, Q. Solution-processable, durable, scalable, fluorine-grafted graphene-based superhydrophobic coating for highly efficient oil/water separation under harsh environment. New J. Chem. 2018, 42, 3819. [Google Scholar] [CrossRef]
- Sadanandan, K.S.; Bacon, A.; Shin, D.W.; Alkhalifa, S.F.R.; Russo, S.; Craciun, M.F.; Neves, A.I.S. Graphene coated fabrics by ultrasonic spray coating for wearable electronics and smart textiles. J. Phys. Mater. 2021, 4, 014004. [Google Scholar] [CrossRef]
- Khan, A.; Winder, M.; Hossain, G. Modified graphene-based nanocomposite material for smart textile biosensor to detect lactate from human sweat. Biosens. Bioelectron. X 2022, 10, 100103. [Google Scholar] [CrossRef]

| Coating Materials | Substrates | Coating Methods | Properties | |||
|---|---|---|---|---|---|---|
| Anti-Bacterial Efficiency (%) | UV Protection Factor | WCA | Resistance/ Conductivity | |||
| rGO [35] | 3/1 twill cotton fabric | dip-pad-dry (5 times) | - | - | - | 36.94 kΩ/sq |
| GO [51] | cotton fabric | suction filtration (3 times) | 98% (E. coli) | - | - | - |
| GO [53] | cotton fabric | dip and dry (3 times) | ~70% (E. coli); 93% (S. iniae) | - | - | - |
| rGO/organosilicon [55] | plain-woven cotton fabric (145 g m−2) | dip-pad-dry (4 times); thermal reduction (up to 220 °C) | - | - | 162° | 8.3 MΩ/sq |
| rGO/organosilicon/N-octylamine [55] | plain-woven cotton fabric (145 g m−2) | dip-pad-dry (4 times); thermal reduction (up to 220 °C) | - | - | 150° | 290 MΩ/sq |
| rGO/organosilicon/tert-butylamine [55] | plain-woven cotton fabric (145 g m−2) | dip-pad-dry (4 times); thermal reduction (up to 220 °C) | - | - | 168° | 55 MΩ/sq |
| rGO/QSA [56] | cotton fabric | dip-dry (10 cycles); chemical reduction | 79.89% (S. aureus); 64.86% (E. coli) | 346 | 145.2° | 4.4 kΩ/sq |
| rGO/QSA/Chlorine [56] | cotton fabric | dip-dry (10 cycles); chemical reduction; dip in bleach solution and then dry | 100% (S. aureus); 100% (E. coli) | 323 | 153.6° | ~350–2500 kΩ/sq |
| rGO/Cu NPs [57] | cotton fabric | dip coating in GO dispersion; then dip coating in CuCl2 solution; chemical reduction | 99% (E. coli); 99% (C. xerosis); 99% (M. luteus) | - | 160° | - |
| rGO/Ag NPs [58] | nonwoven fabric (50% rayon, 50% polyester) | spray coating of GO; electrochemical reduction; electrodeposition of Ag NPs | 99.99% (E. coli) | - | 148° | ~0.024 S cm−1 |
| GO [63] | cotton fabric | dip-dry | 95.6% (E. coli); 87.6% (S. aureus) | 13.5 | - | - |
| GO/ZnO quantum dots [64] | cotton fabric | dip-pad-dry | - | 61.3 | - | - |
| rGO [65] | Cotton spun lace nonwoven fabric (70 g m−2) | dip-dry (5 times); chemical reduction | - | 167.3 | 108.2° | 598 Ω/sq |
| rGO [66] | plain-woven polyamide fabric | electrophoretic deposition of GO; thermal reduction (210 °C) | - | >500 | 96.7° | 3.3 S m−1 |
| rGO/Cu NPs [67] | plain-woven cotton fabric | dip coating in GO dispersion, then dry (3 times); dip in the CuSO4 solution and then dry; chemical reduction and thermal treatment | - | 46.45 | ~150° | 6.42 kΩ/sq |
| rGO/Ag NPs [67] | plain-woven cotton fabric | dip coating in GO dispersion, then dry (3 times); dip in the AgNO3 solution and then dry; chemical reduction and thermal treatment | - | 35.31 | ~150° | 52 kΩ/sq |
| rGO [84] | plain-woven cotton fabric (120 g m−2) | dip-dry (3 times); thermal reduction (up to 250 °C) | - | 35.8 | 125° | ~104 Ω m−2 |
| rGO/organosilicon [85] | plain-woven cotton fabric (145 g m−2) | dip-dry (4 times); thermal reduction (up to 220 °C) | - | - | 153° | 2.7 MΩ/sq |
| rGO [86] | polyester fabric (110 g m−2) | dip-dry; chemical reduction | - | - | 123° | 1.3 kΩ/sq |
| rGO [88] | plain-woven cotton fabric (~145 g m−2) | dip-pad-dry (4 times); and then dip in the Irganox 1010 solution; thermal reduction (up to 220 °C) | - | - | 142.4° | 3.7 MΩ/sq |
| rGO/MTCS [88] | plain-woven cotton fabric (~145 g m−2) | dip-pad-dry (4 times); and then dip in the Irganox 1010 solution; thermal reduction (up to 220 °C); dip in the MTCS solution | - | - | 171.1° | 8.3 MΩ/sq |
| rGO/SiO2 NPs [89] | plain-woven cotton fabric (~160 g m−2) | spray-coating; thermal reduction (180 °C) | - | - | 151.4° | |
| rGO/SiO2 NPs/polyurethane [90] | cotton fabric | rod coating and then dry | - | - | 153.9° | - |
| rGO/PDA/Cu NPs/stearic acid [91] | cotton fabric | dip-dry (3 times); chemical reduction; dip in the CuSO4 solution | - | - | 153° | 6769 S m−1 |
| rGO/PDMS/TiO2 [92] | plain-woven cotton fabric (~127 g m−2) | dip-dry (4 times); dip in the solution of OH-PDMS-OH and Ti(OBu)4; chemical reduction | - | - | 159.3° | 0.76 kΩ cm−1 |
| rGO/CuS/PDMS [93] | cotton fabric | dip-pad-dry-cure | - | 851.2 | 158.4° | - |
| rGO [95] | polyester fabric | ultrasonic spray coating | - | - | ~60° | ~120 kΩ/sq |
| rGO [95] | nylon fabric | ultrasonic spray coating | - | - | ~32° | 45 kΩ/sq |
Disclaimer/Publisher’s Note: The statements, opinions and data contained in all publications are solely those of the individual author(s) and contributor(s) and not of MDPI and/or the editor(s). MDPI and/or the editor(s) disclaim responsibility for any injury to people or property resulting from any ideas, methods, instructions or products referred to in the content. |
© 2023 by the authors. Licensee MDPI, Basel, Switzerland. This article is an open access article distributed under the terms and conditions of the Creative Commons Attribution (CC BY) license (https://creativecommons.org/licenses/by/4.0/).
Share and Cite
Liu, Y.; Fei, B.; Xin, J.H. Functionalization of Fabrics with Graphene-Based Coatings: Mechanisms, Approaches, and Functions. Coatings 2023, 13, 1580. https://doi.org/10.3390/coatings13091580
Liu Y, Fei B, Xin JH. Functionalization of Fabrics with Graphene-Based Coatings: Mechanisms, Approaches, and Functions. Coatings. 2023; 13(9):1580. https://doi.org/10.3390/coatings13091580
Chicago/Turabian StyleLiu, Yang, Bin Fei, and John H. Xin. 2023. "Functionalization of Fabrics with Graphene-Based Coatings: Mechanisms, Approaches, and Functions" Coatings 13, no. 9: 1580. https://doi.org/10.3390/coatings13091580
APA StyleLiu, Y., Fei, B., & Xin, J. H. (2023). Functionalization of Fabrics with Graphene-Based Coatings: Mechanisms, Approaches, and Functions. Coatings, 13(9), 1580. https://doi.org/10.3390/coatings13091580

